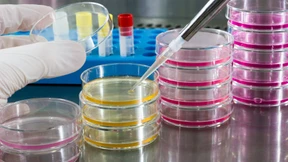
Die Mischung macht‘s

Apotheken stellen jetzt Impfnachweise aus
Seit Montag können sich vollständig Geimpfte den QR-Code für ihren digitalen Impfpass abholen. Die Apotheken bitten allerdings um Geduld. Noch machen nicht alle von ihnen mit.

Seit Montag können sich vollständig Geimpfte den QR-Code für ihren digitalen Impfpass abholen. Die Apotheken bitten allerdings um Geduld. Noch machen nicht alle von ihnen mit.

Ein einziger Kreis in Hessen liegt derzeit über der Inzidenz von 50. Sonst befindet sich das Bundesland in einem stabilen Bereich. der von heute an erhältliche digitale Impfnachweis könnte für Chaos bei Apotheken sorgen.

Per E-Mail hatte Berlins Gesundheitssenatorin Dilek Kalayci (SPD) die Erlaubnis für eine mobile Teststelle des Bundestagsabgeordneten Thomas Heilmann zurückgezogen. Der wehrt sich jetzt mit juristischen Mitteln.

In Hessen geht die zentrale Corona-Kennziffer minimal zurück. Zwei Kreise liegen nun unter der Inzidenzmarke fünf. Frankfurt bereitet die Ausgabe des digitalen Impfpasses von Montag an vor.

„Überkompensation zu Gunsten der Apotheken“ und „unerwünschte Mitnahmeeffekte“ von Krankenhäusern – der Bundesrechnungshof geht mit den Corona-Maßnahmen der Regierung hart ins Gericht und fordert künftig Änderungen.

Vollständig geimpfte Menschen sollen in Kürze ihre Immunisierung mit einem digitalen Impfzertifikat über das Handy nachweisen können. Die Einführung dieses Digital-Passes in Deutschland soll am Donnerstag starten.

Mancher Glücksritter hat auf glänzende Geschäfte mit Cannabis gesetzt und ist gescheitert. Aber es gibt auch Unternehmer, die immer noch da sind. Wir haben sie besucht.

An immer mehr Orten werden Corona-Tests angeboten. Nicht jeder Anbieter wirkt dabei seriös. Doch für die Kontrolle sieht sich das Frankfurter Gesundheitsamt nicht zuständig.

Viele Länder haben sich in der Impfstoffversorgung auf Indien verlassen. Das südasiatische Land ist der führende Vakzinhersteller der Welt. Doch nun kommt es zu Engpässen, denn die Regierung in Delhi hat den Eigenbedarf unterschätzt.

Präsident Joe Biden hat den Vereinigten Staaten für den Sommer ein Stück Normalität versprochen: Am 4. Juli sollen wieder Grillfeste möglich sein. Dafür will das Land bis zum Nationalfeiertag 70 Prozent aller erwachsenen Amerikaner einmal geimpft haben.

Indien war einer der größten Exporteure von Corona-Impfstoffen – und wird nun zum Importeur. Dabei wollte Delhi mit seiner „Impfdiplomatie“ Peking das Feld streitig machen. Nun aber muss das Land selbst Hilfe annehmen.

Spahn: Sehr viele Neuinfektionen bei 6- bis 20-Jährigen +++ Nach Sachsen hebt auch Mecklenburg-Vorpommern Impfpriorisierung für Astra-Zeneca-Vakzin auf +++ Polizei löst Demonstration in Berlin auf +++ Alle Entwicklungen im Liveblog.

Die Impfung gegen das Corona-Virus gibt es in den Vereinigten Staaten jetzt an jeder Ecke. Und nicht nur das. Wer sich impfen lässt, bekommt vieles gratis. Das treibt schöne Blüten.

Die seit über einem Jahr andauernde Covid-19-Pandemie hat die Stärken und Schwächen des deutschen Gesundheitssystems wie unter einem Brennglas offengelegt. Viele Beteiligte wollen sich nachhaltig für eine gute Versorgung der Patienten und für eine bessere Gesundheit der Menschen einbringen. Sie sehen Handlungsbedarf, wenn zukünftig Innovationen schneller in die Anwendung kommen sollen. Experten, die selbst gegründet haben, Produkte entwickeln oder die Versorgung von Patienten sicherstellen, berichten über ihre Erfahrungen und zeigen Optionen zur Verbesserung auf.

Der Weg vom Hersteller der Corona-Impfstoffe zu den Ärzten im Rhein-Main-Gebiet ist weit, geht über viele Stationen und dauert Tage. Dabei darf nirgends die Kühlkette unterbrochen werden.

Die Impfkampagne der Bundesregierung kommt nur schleppend voran. Eine Apotheke wollte ihre Kunden daher selbst mit Impfstoff versorgen und klagte. Doch eine Pflicht zum Vertragsabschluss besteht laut Gericht nicht.

Ab April sollen die Hausärzte in die Impfkampagne eingebunden werden, und es wird mehr Impfstoff an die Grenzen geliefert. Dazu bekommen die Apotheken eine entscheidende Rolle. Die Beschlüsse im Überblick.

Seit Anfang März gilt: Schnelltests umsonst für alle. Doch funktioniert das und wie steht es um die Tests in den Regalen vom Discounter? Ein Selbstversuch.

Mit neuen Spezialmedikamenten setzt der Pharmakonzern Stada Akzente. Ein neues Parkinson-Mittel könnte laut dem Vorstandschef „zum Goldstandard“ werden. Auch medizinisches Cannabis kommt in die Apotheken.

Hausärzte sollen ihre Patienten später als angekündigt gegen Corona impfen. Ihr Ärger darüber ist groß. Und viele Fragen sind offen - zum Beispiel die, wie der Impfstoff überhaupt in die Praxen gelangt.
Individualisierte Medizin ermöglicht eine bessere Behandlung chronischer und seltener Krankheiten. Der Trend zu neuartigen Therapien stellt das Gesundheitssystem aber auch vor Herausforderungen.

Von Montag an finanziert der Bund kostenfreie Schnelltests für alle. Das heißt aber nicht, dass sie auch wirklich angeboten werden. Einige Länder geben sich in Bezug auf konkrete Termine zugeknöpft. Ein Überblick.

Der Staat managt die Massenimpfungen gegen Corona mehr schlecht als recht. Nun will eine Kölner Apotheke aushelfen und verklagt den Hersteller Biontech.

Die Familie zuhause testen, bevor sie die Großeltern besucht: Das könnte von nächster Woche an möglich sein. Im Internet gibt es schon Corona-Selbsttests, doch nur drei sind zugelassen.

Gastronomie und Handel hoffen auf Corona-Lockerungen. Doch Kanzlerin Merkel bremst die Erwartungen an Selbsttests und CSU-Chef Söder warnt vor „Öffnungshektik“. Kommunen und Apotheken fordern ein detailliertes Schnelltestkonzept.

Ein weiterer Schritt der Digitalisierung des Gesundheitssystems: Das elektronische Rezept wird Pflicht. Wie das Ganze vom Sommer an funktioniert.

Von März an soll jeder Bürger jederzeit kostenlose Corona-Tests machen können. Der Gesundheitsminister setzt unter anderem auf die Apotheken. Aber wird der Plan funktionieren?

Selbsttests könnten die Testkapazitäten erheblich erweitern. Was in Österreich längst Realität ist, wird in Deutschland jedoch noch einige Zeit dauern. Besonders die Anwendbarkeit sollte ausgiebig geprüft werden.

Mehr als 1,5 Millionen Menschen wurden in Österreich vorige Woche auf das Coronavirus getestet, künftig sollen es bis zu 3,5 Millionen in der Woche sein – in Schulen, Betrieben, Apotheken. Das Land sieht sich als Vorreiter in Europa.

Die Sorge der Menschen um ihre Gesundheit nutzt den Apotheken, könnte man meinen. Doch auch sie leiden in der Pandemie. Zudem quält die Branche weiterhin die Konkurrenz aus dem Internet.

Kredite, Stundungen, Hilfe von der Familie: Nach der Insolvenz des Rezeptabrechners AVP wenden die Apotheken das Schlimmste ab. Doch große Sorgen bleiben.

Damit man sich künftig selbst auf Corona testen kann, will Bundesgesundheitsminister Jens Spahn die Medizinprodukte-Abgabeverordnung laut einem Bericht ändern. Die Tests soll man dann wohl in der Apotheke kaufen können.

Medizinische Masken sind nun Pflicht. Knapp werden sie wahrscheinlich nicht. Und teuer müssen sie auch nicht sein. Wo man sie am besten kauft und was sie höchstens kosten sollten.

In der Corona-Krise schlägt jetzt die Stunde der FFP2-Maske, die nicht nur die Mitmenschen, sondern auch den Träger selbst vor Viren schützt. Apotheker-Preise muss dafür niemand zahlen, und mehrmals verwenden kann man sie auch.

Die Pleite des Rezeptabrechners AVP brachte viele Apotheken in finanzielle Schwierigkeiten. Nun hat die Staatsanwaltschaft Düsseldorf zahlreiche Privat- und Firmenobjekte durchsucht.

Curevac-Gründer Ingmar Hoerr über seine Entdeckung der Technologie für den Corona-Impfstoff, die Abweisung durch Geldgeber – und warum in der Pharmaindustrie kein Stein auf dem anderen bleiben wird.